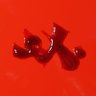
peowstudio's profile picture. The sequel to Peow (1).  Publisher from Sweden just trynna do our thing. Working w/ the best artists ever. email contact{at}peowstudio{dot}com

loukoumh 🏳️🌈
@loukoumh
she/ her 🇬🇷 🇺🇦 illustrator/tattoo apprentice
你可能會喜歡
Happy pride month 🌈 I have sad wounded knight and her gf for u

the way these people talk about palestinians is so dehumanising. fuck off
if you've ever used the orange and pink lesbian flag i designed can you please share this 😭
so in a few weeks im probably going to be homeless and couch surfing again so if anyone has even $1 to help me save for a rental deposit, i would be immensely grateful ko-fi.com/emilygwen
Hind Rajab was 6 and she was shot with 335 bullets.

Charlie Kirk is a father and a husband. He is a human. I don’t care if you politically disagree with him nothing justifies this sick act.

Charlie Kirk shot dead? Here is a list of 230 journalists murdered by Israel in Gaza who Charlie supported

So do actors in the UK just not care about trans people
Harry Potter audiobooks adds 10 to cast: Kit Harington will voice Professor Lockhart; Keira Knightley is Professor Umbridge; Iwan Rheon is Professor Lupin; Ruth Wilson is Bellatrix Lestrange; Ambika Mod is Nymphadora Tonks; Leo Woodall is Bill Weasley; Simon Pegg is Arthur…

I'm Sava, an artist from Ukraine. Last night a Russian missile hit my house and destroyed it - It is impossible to live there. If you have the opportunity, here is my PayPal - [email protected]. I would be grateful for sharing!

hi! I’m Donya and this is my work




Happy Ukrainian Independence Day!

KidLit art without AI 🐅✨




Neil Gaiman is a vile man and my heart just breaks for these women. It's disgusting that not a single major news outlet has further investigated this yet. He has lost all of my respect and I hope everyone refrains from giving him any more money.
Neil Gaiman forced a single mother of 3 to have sex with him under threat of evicting her and her 3 young children--a threat he eventually made good on, which concluded with him forcing her to sign a NDA. tortoisemedia.com/2024/08/01/exc…




Hi #PortfolioDay ! My name is Yara, I’m a kidlit illustrator, who’s currently looking for new projects! My dream would be to illustrate a nonfic book about animals, nature or any sort of weird creatures! 🐛 Rep’d by @jemiscoe at ABLA ✏️ odnatamyara.com




Israel has bombed the tents of displaced Palestinians in the designated safe area. The tents are melting, the people are melting, there are beheaded children and charred bodies beyond recognition. We will not look away. Free Palestine.

BREAKING NOW: Israel is heavily bombing GAZA This is Israel, targeting civilians in the darkness of the night whilst they sleep. This is Israel committing yet another massacre. ALL EYES ON RAFAH
RAFAH WAS NEVER A “SAFE ZONE” IT WAS AN ETHNIC CLEANSING PLAN! TRULY PSYCHOPATHIC!
United States 趨勢
- 1. Josh Allen 38K posts
- 2. Texans 58.5K posts
- 3. Bills 152K posts
- 4. Joe Brady 5,235 posts
- 5. #MissUniverse 433K posts
- 6. #MissUniverse 433K posts
- 7. Anderson 27.6K posts
- 8. McDermott 4,595 posts
- 9. Troy 12.2K posts
- 10. #StrayKids_DO_IT_OutNow 49.3K posts
- 11. #TNFonPrime 3,823 posts
- 12. Maxey 13.5K posts
- 13. Cooper Campbell N/A
- 14. Dion Dawkins N/A
- 15. Al Michaels N/A
- 16. Stroud 3,670 posts
- 17. #criticalrolespoilers 2,162 posts
- 18. Costa de Marfil 25.3K posts
- 19. Shakir 5,660 posts
- 20. Fátima 192K posts
你可能會喜歡
-
 abby memedokies ➰
abby memedokies ➰
@memedokies -
 Tuca Andrada
Tuca Andrada
@TucaAndrada3 -
 Yingzong Xin
Yingzong Xin
@Kiddo_hah -
 Mika, Alex Unknown
Mika, Alex Unknown
@Mikasacus -
 Stéphane
Stéphane
@Stephan95105295 -
 ⚡ Savo ⚡
⚡ Savo ⚡
@savodraws -
 Oh Lenic
Oh Lenic
@ohlenic -
 vic
vic
@irlplasticlamb -
 Elika Takimoto
Elika Takimoto
@elikatakimoto -
 jaya 🍄🌺 🇵🇸 @ arcane brain
jaya 🍄🌺 🇵🇸 @ arcane brain
@ghostlysleuth -
 Peow2
Peow2
@peowstudio -
 『 Jijidraws.art 🦋』🍉
『 Jijidraws.art 🦋』🍉
@jijidraws -
 Every Bald Guy Is Actually Foucault
Every Bald Guy Is Actually Foucault
@EveryBaldGuy -
 ally
ally
@allygnnn
Something went wrong.
Something went wrong.